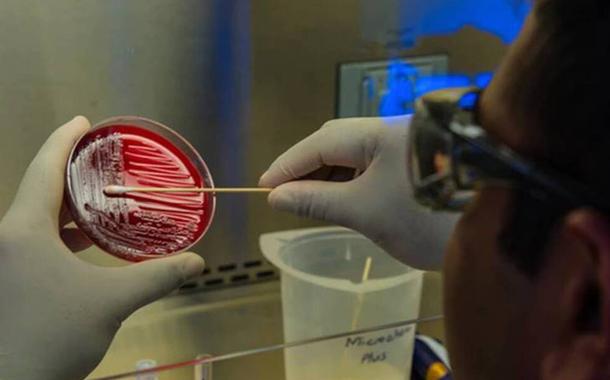

Com 2 milhões de casos, Brasil ultrapassa 80 mil mortes por Covid-19
Nas últimas 24 horas, o País contabilizou novos 632 óbitos e 20.257 casos, segundo o Ministério da Saúde. Desde o início da pandemia do novo coronavírus, já foram 2.118.646 pessoas infectadas e...